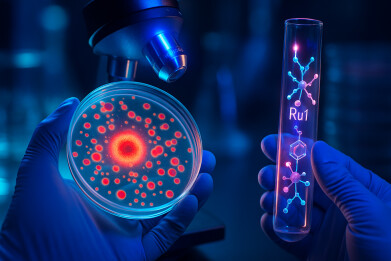
Light-activated ruthenium complex has sensitised drug-resistant E. coli to antibiotics; study

Research news
Light-activated ruthenium complex has sensitised drug-resistant E. coli to antibiotics; study
Dec 16 2025
Light-activated ruthenium chemistry has increased the potency of meropenem against NDM-1-mediated antibiotic-resistant Escherichia coli in laboratory tests, which may point to a controllable strategy for surface-accessible infections and decontamination
Work from the Francis Crick Institute has tested whether flashes of blue light can reverse antibiotic resistance in bacteria, by triggering a light-sensitive metal complex to damage a resistance protein and restore drug potency.
“We’re borrowing a technique from cancer drug discovery, where small molecules are used to degrade specific proteins,” said Lars Stevens-Cullinane, a researcher in the Biological Inorganic Chemistry Laboratory at the Crick. He has reported that his team has adapted the underlying idea for antimicrobial resistance (AMR) but has substituted small molecules with light-responsive metal complexes that only become chemically disruptive when exposed to light.
AMR remains a key global health threat, with widely cited estimates associating it with in excess of four million deaths annually in recent with a steep rise projected by 2050. The pressure has proved particularly acute for infections caused by Gram-negative bacteria such as E. coli, which possess structural barriers that can inhibit drug entry and reduce the effectiveness of a range of treatments.
Dr. Jeannine Hess, who led the work at the Crick and lectures at King’s College London, said that chemistry-based approaches that move beyond incremental antibiotic modification have become increasingly important.
“Many novel antibiotics are improved versions of previous drugs, attacking bacteria in a similar way,” Hess said.
“But making different antibiotics from scratch is challenging and time-consuming. It’s clear we need novel strategies and we think innovative chemistry could hold the answer,” she added.
In their recent study the researchers focused on New Delhi metallo-beta-lactamase 1 – an enzyme commonly known as NDM-1 – that appears in some drug-resistant bacteria and can disable a broad class of antibiotics. Beta-lactam antibiotics include widely used agents such as Penicillins and resistance mechanisms that break the beta-lactam ring can undermine treatments that clinicians have relied on for decades.
“We designed a chemical tool – ‘Ru1’ – composed of a light-activated ruthenium metal complex attached to an organic molecule – a ‘ligand’ – that binds to NDM-1,” Stevens-Cullinane explained. He said that the design aimed to keep the compound comparatively inert without light exposure, but to allow it to generate highly reactive chemical species once illuminated. In this case, blue light activated the ruthenium complex, which then produced reactive oxygen species that damaged the NDM-1 protein.
The team reported that Ru1 combined three functional elements:
- a ligand that recognised and bound NDM-1
- a molecular linker
- a ruthenium complex that responded to light.
In tests that used purified proteins, Ru1 damaged the enzyme’s active site, which prevented NDM-1 from breaking down antibiotics. The researchers reported a strong dependence on light exposure with activity roughly a hundred-fold higher under illumination than in the dark.
The study also reported that the effect depended on continued exposure. When the researchers switched off the light, Ru1 no longer caused damage, which suggested that clinicians might be able to eventually control its activity both spatially and temporally. In principle, such control could help to reduce unwanted off-target effects because the compound would only become disruptive when light was delivered.
The researchers then tested whether the approach translated from purified proteins to living E. coli.
“Although Ru1 did partially inactivate NDM-1 in the live bacteria in the dark, it was thirty times more effective in the light, showing our targeted approach works,” Stevens-Cullinane said. The team also reported that microscopy indicated compound accumulation in the centre of bacterial cells rather than within the cell wall, a distribution that would be consistent with the objective to reach a protein target rather than to act only on the bacterial surface.
In a further set of experiments, the researchers tested whether Ru1 could restore susceptibility to a clinically important antibiotic. They reported that resistant E. coli became sensitised to meropenem by Ru1. Meropenem is a carbapenem antibiotic that is often reserved by clinicians for the most severe infections.
“At the maximum concentration tested, Ru1 increased the activity of meropenem by 53 times,” said Stevens-Cullinane, adding that the team had not observed toxicity to human cells under the experimental conditions reported.
For Hess, the results supported the premise that protein-targeted phototherapy could become a practical tool against AMR, provided that subsequent studies confirm safety and efficacy in more complex systems.
“This is the first time we’ve used phototherapy for this challenge, so we’d need to see how it works in an animal model next,” Hess said.
She also cautioned that blue light has limited penetration into tissue, which would likely constrain early clinical applications.
“As blue light can’t penetrate deep into the body, it most likely would be used for skin infections, dental work, or sterilising medical equipment, rather than treating internal infections.”
Digital Edition
Lab Asia Dec 2025
December 2025
Chromatography Articles- Cutting-edge sample preparation tools help laboratories to stay ahead of the curveMass Spectrometry & Spectroscopy Articles- Unlocking the complexity of metabolomics: Pushi...
View all digital editions
Events
Jan 21 2026 Tokyo, Japan
Jan 28 2026 Tokyo, Japan
Jan 29 2026 New Delhi, India
Feb 07 2026 Boston, MA, USA
Asia Pharma Expo/Asia Lab Expo
Feb 12 2026 Dhaka, Bangladesh